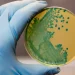

Desde el Alfonso Murube se ha encendido una alerta. Marcos Fernández, destacado jugador del Ceuta y figura emergente de la Liga Hypermotion, ha despertado el interés de diversos clubes europeos de cara al próximo mercado invernal, según informó el experto en transferencias Fabrizio Romano.
El delantero, actualmente cedido por el Espanyol, ha tenido un comienzo de temporada destacado, anotando 5 goles y mostrando un nivel que ha captado la atención fuera de España. Su cláusula de rescisión, establecida en dos millones de euros, es una cifra accesible para equipos con mayor capacidad financiera, lo cual incrementa el interés por este jugador de 22 años.
Fuentes consultadas por AS indican que, si se realiza una venta en el mercado de enero, el Ceuta recibiría un porcentaje del traspaso; una cláusula de protección pactada ante el potencial crecimiento del futbolista, que ya se está materializando. Fernández firmó con el Espanyol el pasado verano para las próximas tres temporadas, tras haber formado parte de la cantera del Betis, donde José Juan Romero —actual entrenador del Ceuta— lo describió recientemente como “el mejor delantero de la categoría”.
Un Ceuta alerta y en búsqueda activa de nuevas opciones
En este contexto, la dirección deportiva del Ceuta, encabezada por Edu Villegas, ha acelerado la búsqueda de delanteros. Esta era una prioridad debido al rendimiento limitado de los fichajes realizados en verano, Juanto Ortuño y Manu Vallejo, pero la posible salida de Marcos obliga a actuar con mayor celeridad.
El club pone especial atención en el mercado de Primera RFEF, su zona habitual para encontrar talento. El objetivo es anticipar cualquier movimiento y evitar quedarse sin tiempo si Marcos decide dar un paso adelante. El jugador es fundamental para el esquema de José Juan Romero: titular indiscutible, líder ofensivo y un delantero moderno que contribuye más allá de los goles por su movilidad y esfuerzo sin balón.
El Espanyol afronta una decisión clave
Mientras su nombre resuena en el panorama europeo, resta por conocer la postura del Espanyol. El club catalán podría optar por renovar su contrato y elevar la cláusula, o bien aprovechar la oportunidad de generar ingresos con una venta de dos millones, dado que incorporó al jugador sin coste el pasado verano.
Con el mercado próximo, el Ceuta está preparado para cualquier resultado. La continuidad de Marcos Fernández es incierta, pero ya ha dejado su huella en la categoría.
Únete al canal de WhatsApp de Más que al día
Recibe las alertas de última hora directamente en tu móvil.
UNIRME GRATIS AL CANAL